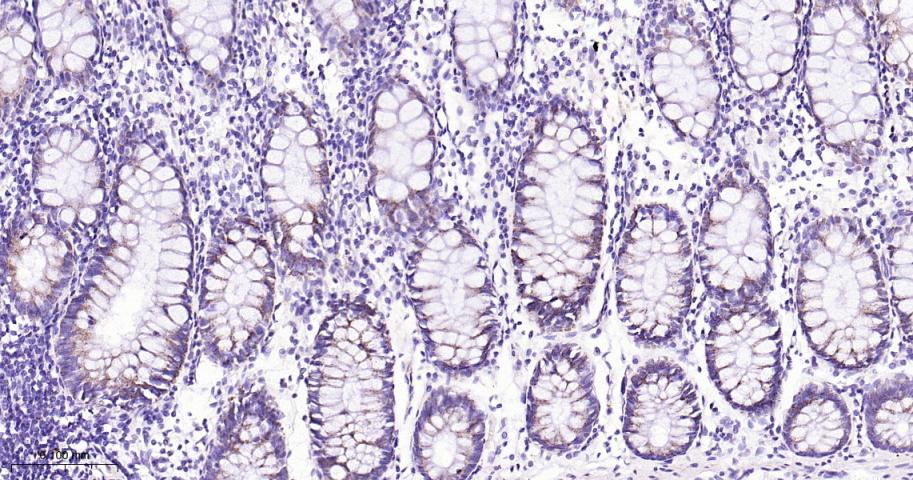
蛋白质酪氨酸激酶JAK-1重组兔单抗

Cancer > Oncoproteins/suppressors > Oncoproteins > Signal transducers
Cancer > Signal transduction > Protein phosphorylation > Tyrosine kinases
Cell Biology > Apoptosis > Intracellular > Kinases
Epigenetics and Nuclear Signaling > Nuclear Signaling Pathways > STATs
Signal Transduction > Protein Phosphorylation > Tyrosine Kinases

| 应用 | 已检合格种属 | 预测种属 | 推荐稀释比例 |
|---|---|---|---|
| WB | Human, Mouse, Rat | 1:500-1000 | |
| IHC-P | Human, Mouse, Rat | 1:100-500 | |
| IHC-F | Human, Mouse, Rat | 1:100-500 | |
| IF | Human, Mouse, Rat | 1:100-500 | |
| Flow-Cyt | Human | Mouse, Rat | 1:50-100 |
交叉反应: Human, Mouse, Rat
暂无相关产品
暂无标记数据
暂无同靶标产品
暂无相关文献
暂无常见问题